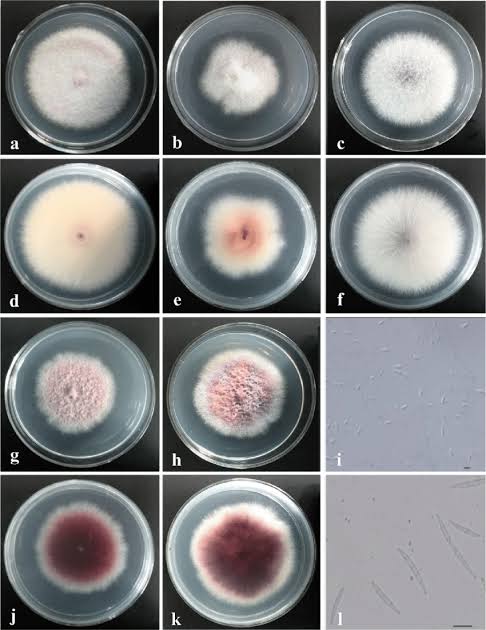

الفيوزاريوم جنس كبير من الفطريات الخيطية يحتوي على أنواع عديدة ممرضة للنباتاتً و تسبب أمراضًا مدمرة لمجموعة واسعة مالمحاصيل الاقتصادية المهمة. فيما يلي أبرز الأنواع الممرضة والأمراض التي تسببها:
أبرز أنواع الفيوزاريوم (Fusarium) الممرضة للنباتات والأمراض المرتبطة بها
1. **الفُيُوزارِيُوم الأُوكْسِيسْبُورُوم (Fusarium oxysporum)** (بأشكاله الخاصة – f. spp.)
* **المرض:** **الذبول الفيوزاريومي (Fusarium Wilt)** (الذبول الوعائي)
* **العوائل والسلالات الخاصة (f. spp.):**
* `f. sp. lycopersici`: الطماطم
* `f. sp. cubense`: الموز (بما في ذلك **مرض بنما (Panama Disease)** المدمر، خاصة السلالة الاستوائية 4 – TR4)
* `f. sp. vasinfectum`: القطن
* `f. sp. niveum`: البطيخ
* `f. sp. pisi`: البازلاء
* `f. sp. asparagi`: الهليون
* `f. sp. dianthi`: القرنفل
* `f. sp. conglutinans`: الملفوف
* … والعديد غيرها (يوجد أكثر من 150 شكلاً خاصاً).
* **الأعراض:** اصفرار، ذبول (غالبًا أحادي الجانب في البداية)، تلون الأوعية باللون البني (تظهر خطوط بنية عند قطع الساق)، تقزم، موت النبات. ينتقل عبر التربة؛ يدخل عبر الجذور ويسد أوعية الخشب.
2. **الفُيُوزارِيُوم الجرامينيارم (Fusarium graminearum)** (وأنواع وثيقة الصلة مثل *F. asiaticum*, *F. meridionale*, *F. boothii* في *مجموعة أنواع F. graminearum*)
* **المرض:** **تبقع السنابل الفيوزاريومي (Fusarium Head Blight – FHB)** أو **الجرب (Scab)** (على القمح/الشعير)، **عفن سنبلة الجبريللا (Gibberella Ear Rot)** (على الذرة/الذرة الشامية).
* **العوائل:** أساسًا القمح، الشعير، الشوفان، الجاودار، الذرة/الذرة الشامية.
* **الأعراض:** تبييض السنيبلات/رؤوس البذور (القمح/الشعير)، عفن وردي على الحبوب المصابة، حبوب ضامرة (“قبور” – tombstone). عفن الساق في الذرة.
* **عامل حاسم:** تنتج **السموم الفطرية (mycotoxins)** شديدة الفعالية، خاصةً **ديوكسي نيفالينول (Deoxynivalenol – DON/فوموتوكسين)** و**زيرالينون (Zearalenone – ZEN)**، مما يلوث الحبوب ويشكل خطرًا صحيًا جسيماً على البشر والماشية.
3. **الفُيُوزارِيُوم فيرتيسيليوديس (Fusarium verticillioides)** (مرادف *F. moniliforme*) و **الفُيُوزارِيُوم بروليفيراتم (Fusarium proliferatum)**
* **المرض:** **عفن كوز الفيوزاريوم (Fusarium Ear Rot)** أو **عفن الكوز الوردي (Pink Ear Rot)** (على الذرة/الذرة الشامية)، ويسبب أيضًا عفن الساق وأمراض البادرات.
* **العوائل:** أساسًا الذرة/الذرة الشامية، أيضًا الذرة الرفيعة، الأرز، الهليون.
* **الأعراض:** عفن أبيض إلى وردي على الحبوب، غالبًا متفرق أو بنمط “نجمي”؛ تعفن الحبوب. قد تكون الحبوب مصابة داخليًا دون أعراض ظاهرة.
* **عامل حاسم:** تنتج **الفيومونيزينات (Fumonisins – FB1, FB2، إلخ)**، سموم فطرية مرتبطة بسرطان المريء عند البشر ومرض اعتلال بيضاء الدماغ (leukoencephalomalacia – LEM) في الخيول، والوذمة الرئوية في الخنازير، وسرطان الكبد في القوارض.
4. **مجموعة أنواع الفُيُوزارِيُوم سولاني (Fusarium solani species complex – FSSC)**
* **المرض:** **تعفن الجذور، تقرحات الساق، تعفن الثمار.**
* **العوائل:** نطاق عوائل واسع جدًا، يشمل:
* `F. solani f. sp. pisi`: تعفن جذور البازلاء
* `F. solani f. sp. phaseoli`: تعفن جذور الفاصوليا
* `F. solani f. sp. glycines`: متلازمة الموت المفاجئ (Sudden Death Syndrome – SDS) في فول الصويا
* `F. solani f. sp. cucurbitae`: تعفن التاج والقاعدة في القرعيات (مثل القرع، البطيخ)
* يسبب تعفن الدرنات في البطاطس، تقرحات الساق على الأشجار، تعفن الثمار (مثل الحمضيات).
* **الأعراض:** آفات سوداء على الجذور/الساق، تعفن الجذور، ذبول، تقزم، موت النبات، تعفن الثمار. غالبًا ما ينتقل عبر التربة.
5. **الفُيُوزارِيُوم كولموروم (Fusarium culmorum)**
* **المرض:** **تبقع سنابل الفيوزاريوم (FHB)/الجرب (Scab)** (الحبوب)، **تعفن التاج (Crown Rot)** (الحبوب)، **تعفن الجذور** (متنوع).
* **العوائل:** القمح، الشعير، الجاودار، الشوفان، الأعشاب.
* **الأعراض:** أعراض مشابهة لـ *F. graminearum* في تبقع السنابل (تبييض السنيبلات، عفن وردي)، تغير لون بني عند قاعدة الساق (تعفن التاج)، تعفن الجذور.
* **عامل حاسم:** تنتج أيضًا سموم **ديوكسي نيفالينول (DON)** و**زيرالينون (ZEN)** الفطرية. تميل إلى أن تكون أكثر أهمية في المناخات الباردة مقارنة بـ *F. graminearum*.
6. **الفُيُوزارِيُوم سودوجرامينيارم (Fusarium pseudograminearum)** (سابقًا *F. graminearum* Group 1)
* **المرض:** **تعفن التاج (Crown Rot)** (أساسًا).
* **العوائل:** القمح، الشعير، حبوب أخرى.
* **الأعراض:** نخر بني شديد عند تاج النبات (القاعدة)، يؤدي إلى ظهور سنابل بيضاء (موت مبكر)، تفريع ضعيف، انخفاض المحصول.
* **عامل حاسم:** معترف به بشكل متزايد كتهديد رئيسي في المناطق شبه القاحلة لزراعة القمح. ينتج DON.
7. **الفُيُوزارِيُوم أفيناسيوم (Fusarium avenaceum)**
* **المرض:** **تبقع سنابل الفيوزاريوم (FHB)/الجرب (Scab)** (الحبوب)، **تعفن الجذور**، **تعفن الثمار** (مثل التفاح، الكمثرى).
* **العوائل:** الحبوب (القمح، الشعير، الشوفان)، البقوليات (البازلاء)، البطاطس، فواكه متنوعة.
* **الأعراض:** أعراض تبقع السنابل، تعفن الجذور، تعفن الثمار.
* **عامل حاسم:** تنتج سموم فطرية مثل **المونيليفورمين (Moniliformin)** و**الإينياتينات (Enniatins)**.
8. **الفُيُوزارِيُوم إكويستي (Fusarium equiseti)**
* **المرض:** **موت البادرات، تعفن الجذور، تعفن الثمار.**
* **العوائل:** نطاق عوائل واسع يشمل الحبوب، البقوليات، البطاطس، الجزر، القرعيات.
* **الأعراض:** إغماد البادرات (damping-off)، تعفن الجذور، آفات الساق، تعفن الثمار (غالبًا في التخزين).
9. **الفُيُوزارِيُوم فوجيكوروي (Fusarium fujikuroi)** (ضمن *مجموعة أنواع Gibberella fujikuroi*)
* **المرض:** **مرض الباكاناي (Bakanae Disease)** (“البادرات الحمقاء” – “Foolish Seedling”).
* **العوائل:** أساسًا الأرز.
* **الأعراض:** إطالة مفرطة (انتصاب – etiolation) للبادرات، تلون باهت، تفريع منخفض، عقم، موت النبات. ينتقل عبر البذور.
* **عامل حاسم:** تنتج هرمون النبات **الجبرلين (Gibberellin)**، مسببة نموًا غير طبيعي.
خصائص رئيسية لأمراض الفيوزاريوم
* **البقاء Survivals :** فطريات الفيوزاريوم الممرضة هي رمية تربة ممتازة، تبقى لسنوات كـ**أبواغ حدارية (chlamydospores)** سميكة الجدار أو على بقايا المحاصيل.
* **الانتشار:** حركة التربة، البذور المصابة، الأبواغ المحمولة بالرياح (الماكركونيديا – macroconidia)، رذاذ الماء، المعدات الملوثة.
* **العدوى:** أساسًا عبر الجذور، الجروح، أو الفتحات الطبيعية. أمراض الذبول الوعائي تغزو نسيج الخشب.
* **السموم الفطرية (Myootcxins):** تنتج العديد من الأنواع سموم فطرية ضارة (DON, NIV, ZEN, Fumonisins, T-2/HT-2, Moniliformin, Enniatins, Beauvericin) تلوث الطعام والعلف، مسببة مشاكل صحية خطيرة.
* **تحديات المكافحة:** صعبة بسبب بقاء الفطر في التربة، نطاق عوائل واسع (لبعضها)، انتقاله بالبذور، وتطور مقاومة للمبيدات الفطرية. إدارة متكاملة للآفات (IPM) ضرورية:
* أصناف مقاومة (حيثما توفرت)
* تناوب المحاصيل (دورات طويلة مع غير العوائل)
* بذور خالية من الممرض
* تحسين صحة التربة
* مبيدات فطرية (معاملات البذور، رشات للمجموع الخضري لمكافحة جرب السنبلة – التوقيت حاسم)
* النظافة الزراعية (إزالة بقايا المحاصيل)
* إدارة الحصاد والتخزين السليم (لتقليل خطر السموم الفطرية)
* عوامل المكافحة الحيوية إذا توفرت.

صحة النبات – Plant Health كل مايخص امراض وصحة النبات

